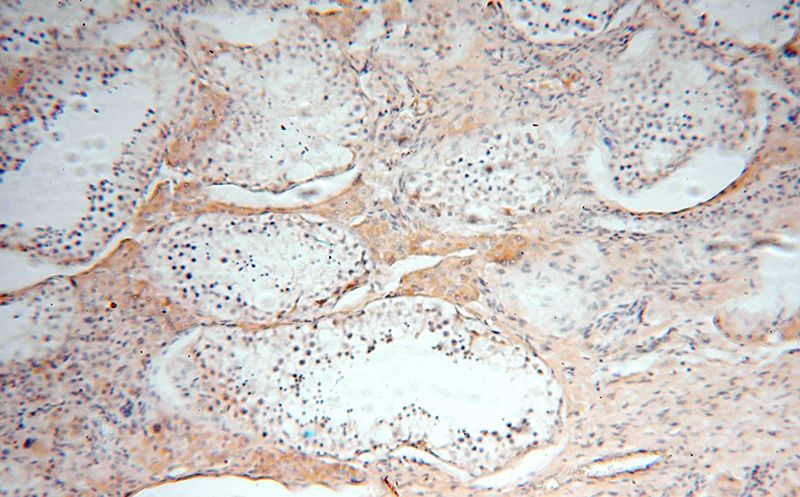
Immunohistochemical of paraffin-embedded human testis using Catalog No:113082(NDUFS3 antibody) at dilution of 1:50 (under 10x lens)

-
Product Name
NDUFS3 antibody
- Documents
-
Description
NDUFS3 Rabbit Polyclonal antibody. Positive WB detected in human heart tissue, HEK-293 cells, HepG2 cells, human skeletal muscle tissue, mouse heart tissue, mouse skeletal muscle tissue. Positive IP detected in mouse heart tissue. Positive IHC detected in human testis tissue, human kidney tissue, human liver cancer tissue. Positive IF detected in HepG2 cells. Observed molecular weight by Western-blot: 30 kDa
-
Tested applications
ELISA, WB, IHC, IF, IP
-
Species reactivity
Human,Mouse,Rat; other species not tested.
-
Alternative names
CI 30kD antibody; Complex I 30kD antibody; NDUFS3 antibody
-
Isotype
Rabbit IgG
-
Preparation
This antibody was obtained by immunization of NDUFS3 recombinant protein (Accession Number: NM_004551). Purification method: Antigen affinity purified.
-
Clonality
Polyclonal
-
Formulation
PBS with 0.02% sodium azide and 50% glycerol pH 7.3.
-
Storage instructions
Store at -20℃. DO NOT ALIQUOT
-
Applications
Recommended Dilution:
WB: 1:200-1:1000
IP: 1:200-1:2000
IHC: 1:20-1:200
IF: 1:10-1:100
-
Validations

human heart tissue were subjected to SDS PAGE followed by western blot with Catalog No:113082(NDUFS3 antibody) at dilution of 1:300
Immunohistochemical of paraffin-embedded human testis using Catalog No:113082(NDUFS3 antibody) at dilution of 1:50 (under 10x lens)

Immunohistochemical of paraffin-embedded human testis using Catalog No:113082(NDUFS3 antibody) at dilution of 1:50 (under 40x lens)

Immunofluorescent analysis of HepG2 cells using Catalog No:113082(NDUFS3 Antibody) at dilution of 1:25 and Rhodamine-Goat anti-Rabbit IgG

IP Result of anti-NDUFS3 (IP:Catalog No:113082, 4ug; Detection:Catalog No:113082 1:500) with mouse heart tissue lysate 4000ug.
-
Background
NDUFS3(NADH dehydrogenase [ubiquinone] iron-sulfur protein 3, mitochondrial) is also named as CI-30kD and belongs to the complex I 30 kDa subunit family. It catalyzes the oxidation of NADH, with the concomitant reduction of ubiquinone and ejection of protons out of the mitochondria(PMID:10967146). NDUFS3 can be used as a mitochondrial matrix control(PMID:17344420). The full length has a transit peptide with 36 amino acids.
-
References
- Shen SM, Yu Y, Wu ZX, Zheng Y, Chen GQ, Wang LS. Apoptosis-inducing factor is a target gene of C/EBPα and participates in adipocyte differentiation. FEBS letters. 585(14):2307-12. 2011.
- Zhang Q, Xiao X, Li M. Telmisartan improves kidney function through inhibition of the oxidative phosphorylation pathway in diabetic rats. Journal of molecular endocrinology. 49(1):35-46. 2012.
- Zhang Q, Xiao X, Li M. Gene expression profiling in glomeruli of diabetic nephropathy rat. Experimental biology and medicine (Maywood, N.J.). 237(8):903-11. 2012.
- Zeng HL, Rao X, Zhang LK. Quantitative proteomics reveals olfactory input-dependent alterations in the mouse olfactory bulb proteome. Journal of proteomics. 109:125-42. 2014.
- Aras S, Bai M, Lee I, Springett R, Hüttemann M, Grossman LI. MNRR1 (formerly CHCHD2) is a bi-organellar regulator of mitochondrial metabolism. Mitochondrion. 20:43-51. 2015.
- Shen SM, Guo M, Xiong Z. AIF inhibits tumor metastasis by protecting PTEN from oxidation. EMBO reports. 16(11):1563-80. 2015.
Related Products / Services
Please note: All products are "FOR RESEARCH USE ONLY AND ARE NOT INTENDED FOR DIAGNOSTIC OR THERAPEUTIC USE"
